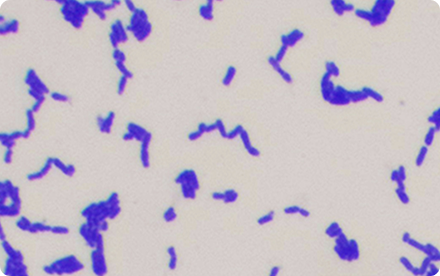
Bifidobacterium animalis subsp. lactis HN019
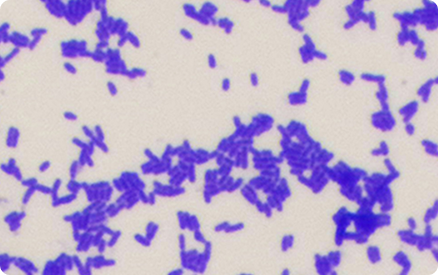
Bifidobacterium animalis subsp. lactis B420

- Cravings calmed
- Less bloating & gas
- Daily calorie intake drops by ~320 kcal
Tired of diets?
Let science do the work.
Science-backed ingredients deliver real results on efficacy of weight management.
- 22+
- Years of Probiotic Expertise
- 328
- Scientific Studies
- 100,000+
- Strains in our Library
- 300+
- Clinical Trials